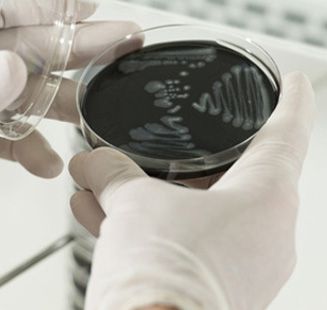

Especialistas en control de plagas. Resultados garantizados, al mejor precio.
La legionelosis es una enfermedad causada por la bacteria Legionella pneumophila que presenta dos manifestaciones clínicas, la "Fiebre de Pontiac" y la "Enfermedad del Legionario"; variando sus efectos desde una afectación del estado general hasta una neumonía atípica e incluso la muerte.
La infección por Legionella puede ser adquirida por vía respiratoria en dos ámbitos, el comunitario y el hospitalario. Para que una instalación presente riesgo de presencia y proliferación de Legionella es indispensable que utilice agua para su funcionamiento y que posea un mecanismo de producción de aerosoles.
El Real Decreto 865/2003 establece los criterios higiénico-sanitarios para la prevención y control de la legionelosis, enumerando las instalaciones en función de su probabilidad de proliferación y dispersión de la Legionella. Las torres de refrigeración, los condensadores evaporativos, los sistemas de agua fría - agua caliente sanitaria con acumulación y retorno, los jacuzzis y las bañeras de hidromasaje se consideran las instalaciones de mayor probabilidad de proliferación y dispersión de Legionella.
BIODAL ofrece un completo servicio de mantenimiento de todos estos tipos de instalaciones, así como de aquellas que presentan menor riesgo. Éste incluye diferentes medidas preventivas, la elaboración de planos señalizados y actualizados, la revisión y examen de todas las partes de la instalación, el establecimiento de los puntos críticos, de los parámetros a medir y los procedimientos a seguir, el diseño de programas de tratamiento de agua, limpieza y desinfección. Todo ello con la periodicidad que marca el citado Real Decreto en función de cada tipo, así como los tratamientos de choque en el caso de detectarse la presencia de la bacteria.
Todos nuestros técnicos están debidamente cualificados habiendo realizado los cursos obligatorios según la legislación vigente.